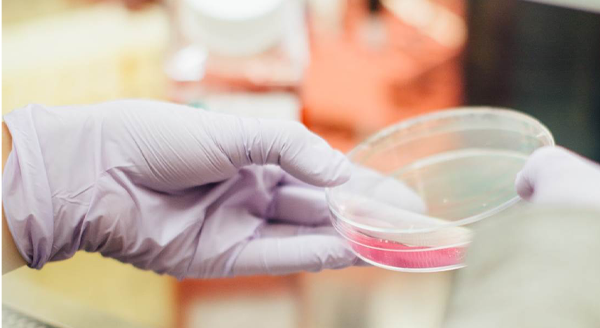

Quality that makes you shine
Gold Ration own production facility, located in California, USA, meets modern quality standards for safety and quality management standards in accordance with ISO 22000, has passed NSF (American National Public Health and Safety Agency) certification and received GMP (Good Manufacturing Practice), which allows us to remain a leader in the safety and quality of nutraceutical products.

At each stage of the production process, Gold Ration products undergo strict quality control under 100% supervision of the company’s quality specialists and with regular monitoring by the FDA (Food and Drug Administration) to ensure the effectiveness of control of all quality parameters of manufactured products.

Gold Ration has the ability to track and test raw materials from harvest to delivery to temperature and humidity controlled storage.
After the own laboratory confirms the purity and freshness of each ingredient, they enter the production.
After the own laboratory confirms the purity and freshness of each ingredient, they enter the production.

The Gold Ration innovative approach is aimed at studying and regularly monitoring the latest scientific achievements in the field of nutrition, medicine and pharmacology. The focus on innovation allows the company not only to maintain the optimal line of essential products for maintaining health and longevity, but also allows us to annually release new unique products with complex formulas that have proven their effectiveness.
Through our innovative openness, we are exploring new systems for delivering beneficial nutrients to the body, increasing the effectiveness of supplements, and regularly examining how individual nutrients interact with each other to find effective combinations.
That is why Gold Ration brand products are gaining more and more trust from consumers around the world every year.
That is why Gold Ration brand products are gaining more and more trust from consumers around the world every year.

Got a question? We’d love to help.
Explore expert answers to some of the most frequently asked nutrition questions.
Vitamins are essential for growth and development. One key nutrient is vitamin D, which helps build strong bones and aids in growth and development. ... Minerals can affect motor and cognitive development. ... Vitamins and minerals boost your immune system.
The human body needs 13 essential vitamins. They are vitamins A, C, D, E, K, and the B vitamins: B1 (thiamine), B2 (riboflavin), B3 (niacin), B5 (pantothenic acid), vitamin B6, vitamin B7 (biotin), vitamin B9 (folate) and vitamin B12.
Multivitamins are intended to be used as part of an overall healthy lifestyle. They can help fulfil the nutritional needs in the diet to support people in getting the recommended daily amounts of key vitamins and minerals needed each day. Take multivitamins as part of a healthy diet and exercise routine.
Gold Ration own production facility, located in California, USA, meets modern quality standards for safety and quality management standards in accordance with ISO 22000, has passed NSF (American National Public Health and Safety Agency) certification and received GMP (Good Manufacturing Practice), which allows us to remain a leader in the safety and quality of nutraceutical products.
Based on science and commitment to quality, Gold Ration Nature Biotechnology Company was founded in California, USA in 1995.
We recommend that the product not be used after the expiration date. All our products are assigned an expiration date, which is based upon extensive stability studies. The product is usable until the last day of the month noted on the package.
Dietary supplements are regulated under the FDA through the DSHEA (or the Dietary Supplement Health & Education Act of 1994).


